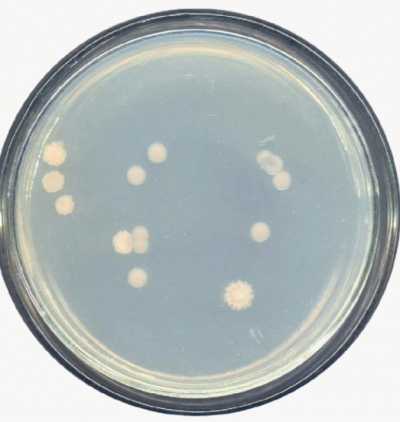
变黄假单胞菌

假单胞菌属

假单胞菌(其他生物相关)假单胞菌pseudomonadaceae为假单胞菌属,该菌
图片尺寸864x686
让人害怕的椰毒假单胞菌
图片尺寸2048x1536
假单胞菌属的介绍
图片尺寸604x600
荧光假单胞菌
图片尺寸240x300
假单胞菌属
图片尺寸300x240
沼泽红假单胞菌
图片尺寸800x661
变黄假单胞菌
图片尺寸400x422
假单胞菌属|2|8
图片尺寸352x289
科研团队发表关于铜绿假单胞菌感染的研究成果
图片尺寸640x434
施氏假单胞菌|北纳生物
图片尺寸622x335
特点:假单胞菌属,革兰氏阴性,有数根极生鞭毛,运动,不产芽孢.
图片尺寸1004x788
假单胞菌科|2|21
图片尺寸220x218
菌铜绿假单胞菌
图片尺寸1200x800
中最常见的是 a target="_blank" href="/item/假单胞菌属/6798543"
图片尺寸1327x1338
cn101603022b_一种施氏假单胞菌菌株及其在降解高分子量多环芳烃中的
图片尺寸1121x1084
上述标本,细菌鉴定结果为铜绿假单胞菌,gram染色在显微镜(×1000)下
图片尺寸600x450
一文了解铜绿假单胞菌
图片尺寸500x375
3d 铜绿假单胞菌细菌的图示照片
图片尺寸533x300
铜绿假单胞菌
图片尺寸1105x691
铜绿假单胞菌
图片尺寸547x410